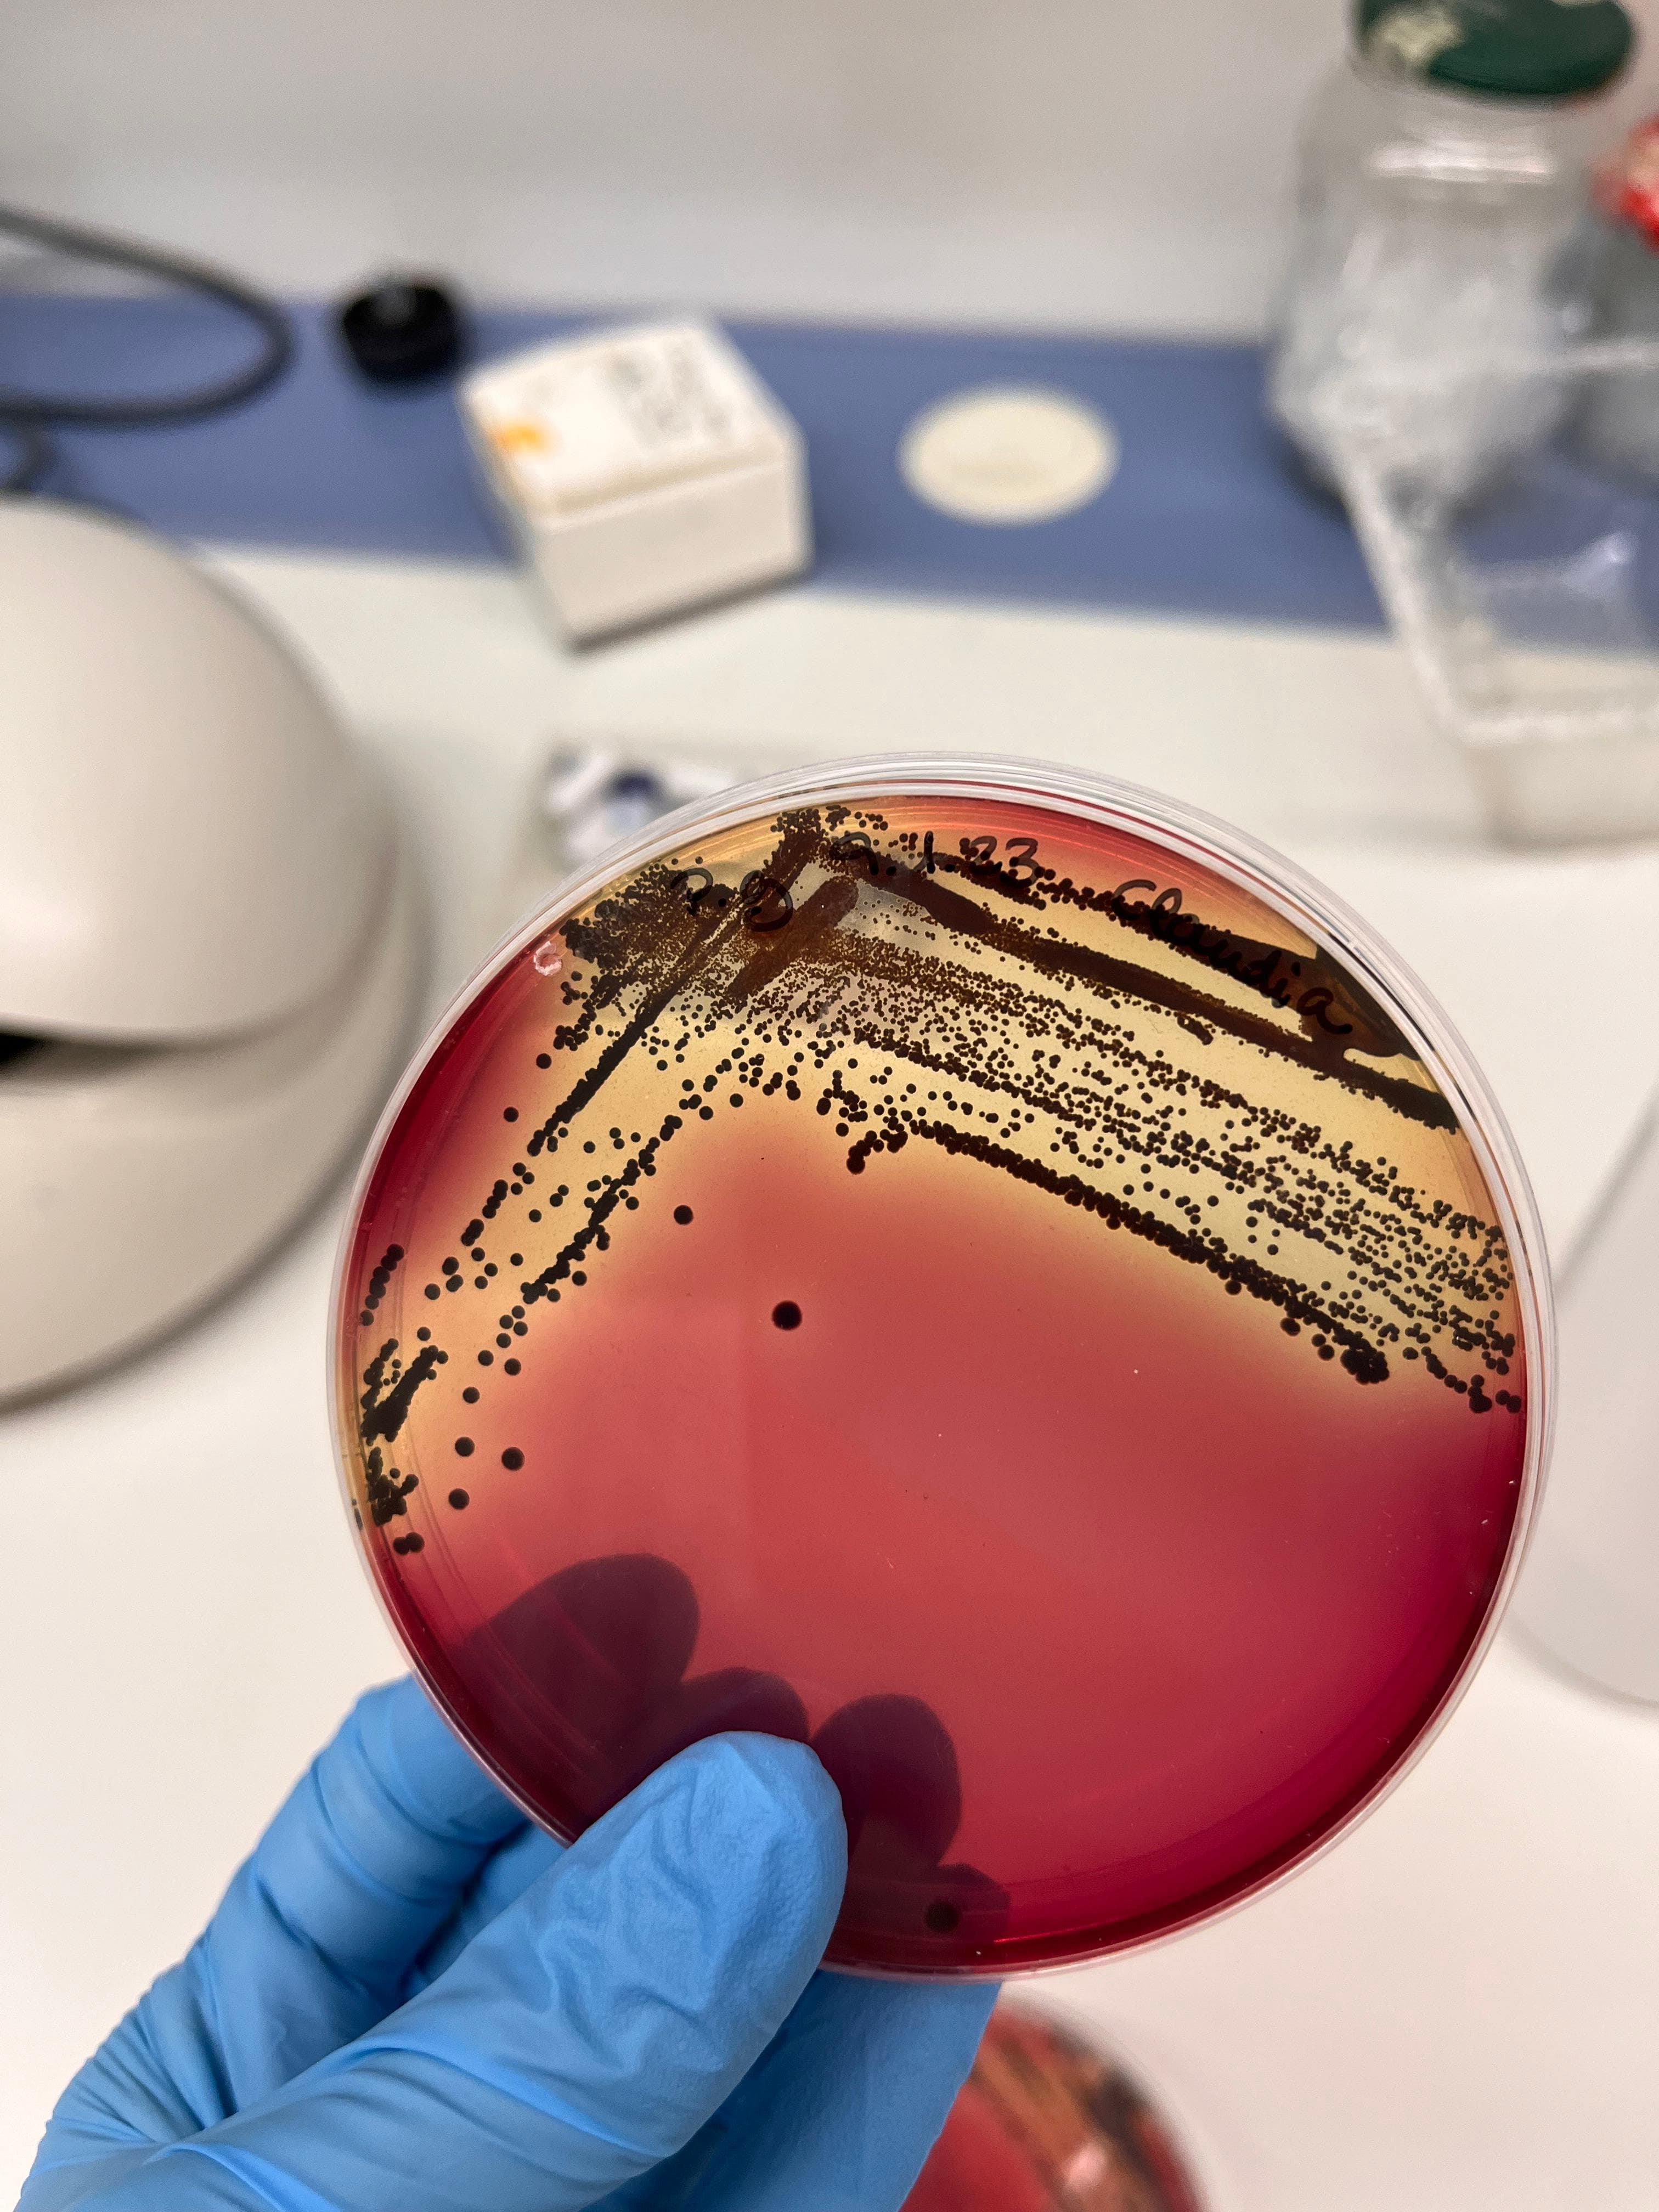
Research Experience

CLAUDIA
PASCUALCLAUDIA PASCUAL|
Research and data analysis in biology and biotechnology. Focused on molecular systems, experimental research, and data-driven discovery.
Scientific illustration by ClaudiaBiologist & Biotechnology
Researcher
Highly motivated molecular biologist with solid experience in biotechnology, microbial biocatalysis, genetic engineering, and bioprocess optimization. Currently completing a Master's Degree in Bioinformatics and Biostatistics at UOC, strengthening competencies in programming, statistical modeling, and computational biology. Transitioning from academia to industry to apply combined wet lab and computational expertise in data driven environments such as genomics, molecular diagnostics, and biotech R&D.

EducationEducation

MSC IN BIOINFORMATICS AND BIOSTATISTICS (UOC, ONGOING). MSC IN MOLECULAR, CELLULAR BIOLOGY AND GENETICS (UNIVERSITAT DE VALÈNCIA). BSC IN BIOLOGY (UNIVERSIDAD DE ALICANTE), AWARDED 'MATRÍCULA DE HONOR' IN PHYSICS.
Research
ExperienceResearch Experience

RESEARCH ASSOCIATE AT THE DE NOVO SYNTHETIC BIOLOGY LAB (CSIC – I2SYSBIO). EXPERIENCE IN GENETIC ENGINEERING, BIOREACTOR MANAGEMENT, PROTOCOL OPTIMIZATION, AND MOLECULAR BIOLOGY TECHNIQUES INCLUDING PCR AND NUCLEIC ACID EXTRACTION.
Computational & Lab
SkillsComputational & Lab Skills

EXPERIENCE IN PYTHON AND R FOR BIOLOGICAL DATA ANALYSIS, INCLUDING BIOCONDUCTOR, DESEQ2, LIMMA, AND GGPLOT. LABORATORY TECHNIQUES INCLUDE PCR, RT-PCR, NUCLEIC ACID EXTRACTION, ANAEROBIC CULTURES, AND SEQUENCING WORKFLOWS.
Conferences &
PublicationsConferences & Publications
SCIENTIFIC ILLUSTRATOR FOR THE TEACHING INNOVATION PROJECT "GAMIFICATION OF IMMUNOLOGY CONTENT FOR LEARNING BASED ON POPULAR GAMES" (REDES-I3CE PROGRAM, 2020–2021). RESULTS PUBLISHED IN THE JOURNAL OF THE SPANISH SOCIETY OF IMMUNOLOGY, 40(3). NRF2 AS A TARGET FOR FRIEDREICH'S ATAXIA C. PASCUAL TOMÀS. PRESENTED AT THE VI CONGRESS OF THE MASTER IN RESEARCH IN MOLECULAR, CELLULAR AND GENETIC BIOLOGY (22 APRIL 2022, BURJASSOT, SPAIN). STUDY OF THE NASOPHARYNGEAL MICROBIOTA ASSOCIATED WITH HEALTH AND DISEASE IN RESPIRATORY INFECTIONS LINKED TO STREPTOCOCCUS PNEUMONIAE A. ADRADOS PLANELL ET AL. PRESENTED AT THE XXIX CONGRESS OF THE SPANISH SOCIETY FOR MICROBIOLOGY (20–23 JULY 2023, BURGOS, SPAIN).